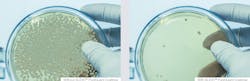
Av Pure Guard Coatings Vergleich 190111 5c3c9c1cd9826 Av Pure Guard Coatings Vergleich 190111 5c3c9c1cd9826

This year Mankiewicz is presenting a new generation of the interior paint ALEXIT PureGuard with active antimicrobial agents to protect the dried paint film. It contains special chemicals that hinder the spread of mould and unpleasant odours, and in this way the paint makes a valuable contribution towards hygiene of surfaces onboard the aircraft. More good news is that the new generation makes it also available as a clearcoat. This opens up many new possibilities for use: the clearcoat can be applied onto almost any surface or substrate – no matter whether foil, existing paint or plastic surfaces. As the clearcoat is itself colourless it does not adversely affect the carefully designed appearance of an aircraft interior. As a matter of course with all Mankiewicz aircraft paints, ALEXIT PureGuard is compliant with the strictest FST demands of the aviation industry. For more information visit www.mankiewicz.com.